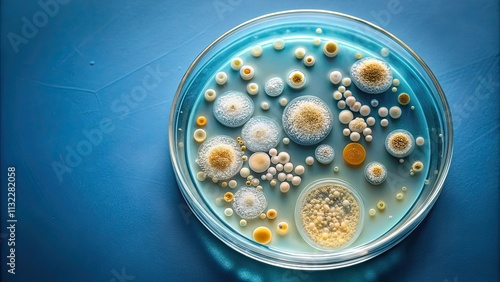
Top view of microorganisms culture, bacteria, cells, microscope, science, biology, research, microscopic, laboratory
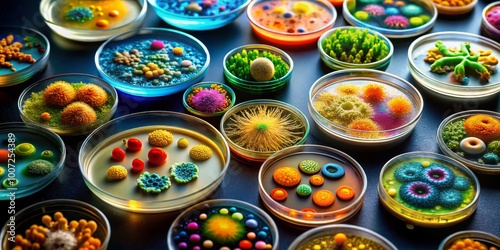
A Colorful Symphony of Life Petri Dishes with Vibrant Microorganism Cultures, Microbiology, Science , Petri Dish

More from this collection

Closeup View Of Colorful Bacteria And Microbes Under A Microscope, Microscopic, Closeup, Bacteria, Microbes

Soil Sample In Plastic Core Box, Lab, Laboratory, Lab, Laboratory, Soil, Earth, Exploration, Core, Nature

Liquid Drop Falling Onto A Test Tube , Science, Experiment, Laboratory, Research, Chemical, Biology, Technology, Liquid

Close Up Of A 96 Well Plate Being Read By An Automatic Plate Reader, Automatic Plate Reader, Laboratory, Research, Technology
Top View Of Microorganisms Culture, Bacteria, Cells, Microscope, Science, Biology, Research, Microscopic, Laboratory
View All from Collection
Explore more designs
Similar Wallpaper designs

Delicious And Healthy Meal Prep: A Colorful Variety Of Foods In Jars

A Scenic Easter Brunch Setting With An Array Of Dishes Including Fruit Pastries And Quiche Arranged On A Table Decorated With Spring Flowers And Pastel Linens

Assorted Dim Sum Dishes With A Variety Of Steamed Dumplings, Buns, And Seafood, Presented In Bamboo Baskets And White Plates.